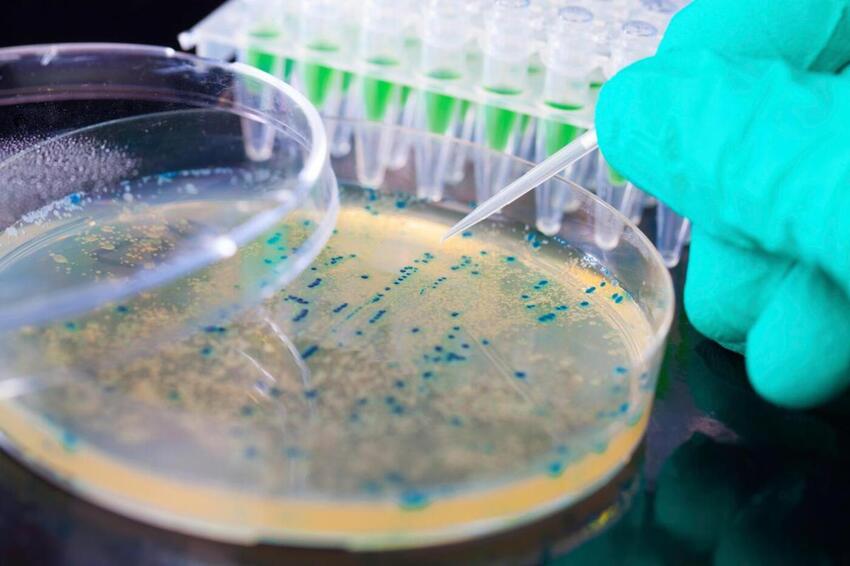
Dit indre liv med billioner af bakterier

Dit indre liv med billioner af bakterier
(Pressefoto)
Men på det seneste er der kastet lys ind i tarmens mørke. Det har givet ny viden om tarmens mylder af mikrober. De fleste er gavnlige og sundhedsfremmende. De omdanner madrester til energi for os. De producerer K-vitamin og nogle B-vitaminer.
Bakterierne spiller en afgørende rolle for vores modstandskraft mod infektioner. Forsøg på dyr viser at nogle af bakteriernes signalstoffer påvirker hjernen.
Gedved Bibliotek streamer tirsdag den 23. oktober en forelæsning, hvor der diskuteres hvorledes ubalancer i tarmbakterier er knyttet sammen med en række kroniske sygdomme. Hør hvad du selv kan gøre for at have tarme i topform med en overvægt af helbredsstabiliserende tarmmikrober.
Arrangementet starter kl. 18.50, og der er gratis billetter på horsensbibliotek.dk og kommunens biblioteker.






















